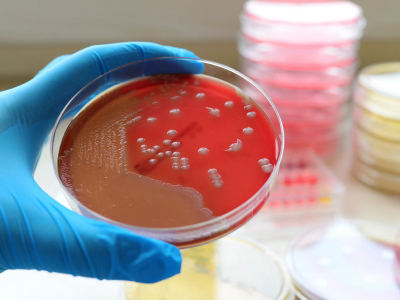

Микоплазмоз у собак
Опубликовано: 17.12.2025
Обновлено: 06.05.2026
Просмотров: 1828
Время чтения: 5 минут

Если ваша собака кашляет, чихает, вялая, и классические анализы не показывают ничего опасного – это может быть микоплазмоз. За 15 лет работы в ветеринарной клинике я сотни раз встречался с этим сложным заболеванием, которое часто диагностируют неправильно или вообще пропускают.
В этой статье ветеринар команды «Мобильный ветеринар» Александр Корчевников раскрыл все аспекты микоплазмоза: что это на самом деле, почему так сложно его диагностировать, какие реальные случаи из моей практики встречались, как правильно лечить и главное – как защитить своего питомца. Будут клинические примеры, советы по профилактике, FAQ и полная библиография научных источников.
Что такое микоплазмоз? Определение и характеристика возбудителя
Микоплазмоз – это инфекционное заболевание, вызываемое микроорганизмами, которые называют микоплазмами. Но важно понимать, что микоплазмы – это не совсем бактерии, не совсем вирусы, а нечто среднее между ними.
Микоплазмоз коварен тем, что симптомы похожи на множество других болезней: насморк похож на простуду, кашель похож на кашель при других инфекциях, конъюнктивит похож на конъюнктивит любого происхождения. И владельцы часто ходят от врача к врачу, лечат симптомы, но не суть болезни.

Что такое микоплазмы?
Микоплазмы – это факультативные внутриклеточные микроорганизмы размером 0,1-0,3 микрона. Для понимания: если воспользоваться аналогией, то обычная бактерия – это мяч размером с апельсин, а микоплазма – это горошина. Они настолько маленькие, что не видны в обычный микроскоп.
Главная особенность микоплазм:
Микоплазмы не имеют клеточной стенки – они защищены только мембраной. Это делает их:
- Устойчивыми к антибиотикам, действующим на клеточную стенку (пенициллины, цефалоспорины)
- Чувствительными только к определенным антибиотикам (тетрациклины, макролиды, линкозамиды)
- Сложными для диагностики – их трудно вырастить на питательных средах
Виды микоплазм у собак
У собак встречаются несколько патогенных видов:
- Mycoplasma cynos
- Это основной возбудитель респираторного микоплазмоза
- Поражает дыхательные пути: носовую полость, трахею, бронхи, легкие
- Вызывает кашель, пневмонию, бронхит
- Обнаруживается у 30-35% здоровых собак в дыхательных путях!
- Mycoplasma canis
- Поражает мочеполовую систему
- Вызывает цистит, уретрит, простатит, вагинит
- Может вызвать бесплодие и проблемы с беременностью
- Mycoplasma haemocanis (Hemotropic mycoplasma)
- Патоген крови – поражает эритроциты
- Опасен для иммунокомпрометированных собак и после спленэктомии (удаления селезенки)
- Вызывает гемолитическую анемию
- Mycoplasma felis (редко)
- Может поражать соединительные ткани
- На собак действует реже, чем на кошек
Нужно понимать: микоплазмы часто живут в организме здоровой собаки как часть нормальной микрофлоры дыхательных путей и мочеполовой системы. Они не вызывают болезнь, пока иммунная система работает нормально. Заболевание развивается при снижении иммунитета или стрессовых состояниях.

Пути передачи и механизм заражения
Понимание путей передачи критично для профилактики. Вот, как микоплазмы передаются от одной собаки к другой.
- Воздушно-капельный путь
Это самый частый путь передачи. Когда инфицированная собака чихает или кашляет, она выделяет в воздух микроскопические капельки слизи с микоплазмами. Здоровая собака вдыхает эти капельки, и микоплазмы оседают на слизистых оболочках дыхательных путей.
Я часто вижу это в питомниках и на выставках собак, где животные находятся на близком расстоянии друг от друга и вероятность заражения резко возрастает. - Контактный путь
- Прямой контакт: облизывание, совместные игры, драки
- Половой контакт: через вагинальную смазку и сперму
- Непрямой контакт: через общие кормушки, миски, игрушки, лежаки
- Гемоконтактный путь (через кровь)
- При переливании крови от инфицированного донора
- При ранениях, укусах, когда кровь попадает в ранку
- Трансплацентарный путь (вертикальная передача)
- От беременной суки к щенкам внутриутробно
- От матери к щенкам через молозиво (первое молоко) в первые часы жизни
- Это особенно опасно, так как щенки рождаются уже инфицированными
Почему микоплазмы распространяются? Микоплазмы выделяются с телесными жидкостями:
- Слюна и слизь из дыхательных путей
- Мочеполовые выделения
- Кровь (для гемотропных видов)
- Молозиво (для беременных сук)
Это объясняет, почему даже непрямой контакт опасен. Микоплазмы сохраняются на предметах какое-то время, поэтому одна грязная кормушка может инфицировать нескольких собак.

Механизм развития болезни: как микоплазмы вредят организму
Поэтапно объясняю, почему микоплазмоз так коварен — болезнь действует поэтапно
Этап 1: Адгезия (прикрепление)
Когда микоплазма попадает на слизистую оболочку, она не сразу вызывает воспаление. Вместо этого она очень плотно прикрепляется к эпителиальным клеткам собаки и буквально начинает из них питаться.
Микоплазма выделяет адгезины – специальные молекулы, которые работают как присоски, прикрепляя микоплазму к клетке хозяина. Это очень коварно, потому что:
- Иммунная система с трудом может атаковать такую хорошо «зарытую» в клетку бактерию
- Антибиотикам сложно пробраться к микоплазме
Этап 2: Питание и выделение токсинов
Микоплазма питается питательными веществами из клетки хозяина, включая нуклеотиды и другие молекулы. При этом она выделяет токсические метаболиты:
- Аммиак – вызывает локальное воспаление и повреждение тканей
- Перекись водорода – окисляет клетки, вызывая их гибель
- Прочие цитопатические вещества – вызывают апоптоз (гибель) клеток
Эти токсины повреждают здоровые клетки слизистой оболочки, вызывая воспаление, отек, выделения.

Этап 3: Иммунное камуфлирование
Здесь микоплазма проявляет свой настоящий коварный ум:
Микоплазма встраивает в свою мембрану антигены клетки хозяина. Это как переодеться в одежду врага. Иммунная система видит микоплазму и думает: «Это же часть нашего собственного организма!» и не атакует.
Одновременно антигены микоплазмы встраиваются в мембрану клетки хозяина. Иммунная система видит инфицированную клетку и думает, что это враг, и убивает её. Получается, что иммунная система атакует собственные клетки!
Это приводит к аутоиммунному воспалению и объясняет, почему:
- Микоплазмоз так сложно лечить
- Болезнь часто переходит в хроническую форму
- Даже после лечения антибиотиками могут быть рецидивы
Этап 4: Распространение по организму
Если иммунная система ослаблена (стресс, другие болезни, плохое питание), микоплазмы могут распространиться из первичного очага (дыхательные пути) на другие органы:
- Суставы (артриты)
- Мочеполовую систему (циститы, простатиты)
- Глаза (конъюнктивиты)
- Слизистые ротовой полости (гингивиты)

Клинические проявления микоплазмоза
Симптомы микоплазмоза очень вариабельны, что делает диагностику сложной. Все зависит от того, какой вид микоплазм поразил собаку и какие органы она предпочтительно поражает.
Форма 1: Респираторный микоплазмоз (Mycoplasma cynos)
Это самая частая форма. Признаки:
Легкие случаи:
- Кашель – обычно сухой или умеренно влажный, часто усиливается после физических упражнений
- Чихание – часто с выделением слизистого отделяемого из носа
- Выделения из носа – от прозрачных слизистых до гнойных желтоватых
- Небольшое повышение температуры – иногда только на 0,5°C
- Слабость и вялость
- Снижение аппетита
Тяжелые случаи (пневмония):
- Частое, затрудненное дыхание – собака дышит ртом
- Одышка даже в состоянии покоя
- Хрипы в легких – слышны при аускультации (прослушивании)
- Кашель с выделением мокроты – может быть кровянистым в тяжелых случаях
- Гипоксия – синюшность слизистых оболочек, язык имеет фиолетоватый оттенок
- Лихорадка (температура выше 39,5°C)
- Отказ от корма
- Сильная слабость
Я видел случаи, когда респираторный микоплазмоз прогрессировал до двусторонней пневмонии за 2 недели, особенно у щенков и старых собак. Это становится опасным для жизни.

Форма 2: Урогенитальный микоплазмоз (Mycoplasma canis)
Микоплазмы поражают мочевой пузырь, уретру, половые органы.
Признаки цистита и уретрита:
- Частое мочеиспускание – собака просит выйти чаще обычного
- Болезненное мочеиспускание – характерная поза напряжения, иногда визжание
- Моча с кровью – розоватый или красный оттенок
- Мутная моча с резким запахом
- Попытки помочиться без результата – тенезмы
Признаки воспаления половых органов:
- У сук: вагинит с выделениями из влагалища (серозные, гнойные или кровянистые)
- У кобелей: баланопостит (воспаление крайней плоти) с отеком мошонки, выделения из пениса
Проблемы с репродукцией:
- У сук: рецидивирующие (повторяющиеся) вагиниты, привычные выкидыши, мертворождение, низкая жизнеспособность щенков
- У кобелей: снижение фертильности (способности к оплодотворению), проблемы с эрекцией, азооспермия (отсутствие сперматозоидов)
Форма 3: Конъюнктивит (поражение глаз)
Признаки:
- Обильное слезотечение (эпифора)
- Блефароспазм – собака щурит глаза из-за боли
- Покраснение конъюнктивы (гиперемия)
- Отек век (хемоз)
- Выделения из глаз – от серозных до гнойных
- Светобоязнь – собака избегает яркого света
- В тяжелых случаях – помутнение роговицы
Важно: Микоплазменный конъюнктивит часто сочетается с респираторной формой, что объясняется близостью дыхательных путей и глазной системы.

Форма 4: Суставная форма (артрит и артроз)
Признаки:
- Хромота – часто перемежающаяся (то на одну ногу, то на другую)
- Нежелание двигаться – собака предпочитает лежать
- Припухлость суставов – видно опухание в области коленей, локтей, запястий
- Боль при пальпации суставов
- Скованность особенно после сна
- Повышение температуры в области суставов
Суставной микоплазмоз может привести к полиартриту (воспаление нескольких суставов одновременно) и даже к хроническому артрозу.
Форма 5: Гемотропный микоплазмоз (Mycoplasma haemocanis)
Эта форма опасна и встречается после переливания крови или при иммунодефиците.
Признаки анемии:
- Бледность слизистых оболочек
- Вялость и слабость
- Одышка при физической активности
- Желтуха (желтоватый оттенок слизистых) в случае гемолиза
- Потемнение мочи (цвет чая)
- Потеря аппетита
- Лихорадка
Форма 6: Поражение слизистой ротовой полости
Признаки:
- Гингивит (воспаление десен) – десны красные, кровоточат, болезненны
- Стоматит – воспаление всей ротовой полости
- Потеря зубов – в тяжелых случаях
- Дурной запах изо рта (галитоз)
- Слюнотечение
- Отказ от корма из-за боли при жевании

Форма 7: Кожная форма
Встречается реже, но иногда микоплазмы поражают кожу:
- Дерматит – красные пятна, шелушение
- Экзема
- Подкожные абсцессы – гнойные капсулы под кожей
- Зуд и расчесы
Общие симптомы при любой форме:
Независимо от формы микоплазмоза, собака часто имеет:
- Повышенную температуру (38,5-39,5°C и выше)
- Вялость и апатию – собака малоактивна, не играет
- Отсутствие аппетита или резко сниженный аппетит
- Жажду с отсутствием голода (неправильное пищевое поведение)
- Потерю веса при длительном течении
- Слабость и быструю утомляемость
- Депрессивное поведение
Клинические случаи из практики
Случай 1: Щенок кокер-спаниеля Тимофей (5 месяцев)
Предыстория: Хозяйка купила щенка 2 месяца назад. Щенок был из питомника с хорошей репутацией, но на 3-м месяце появился легкий кашель. Хозяйка не придала этому значения, думая, что пройдет.
Развитие болезни: За месяц кашель усилился. Щенок вялый, плохо ест. Хозяйка обратилась к местному ветеринару, который выписал общие противокашлевые средства и витамины. Улучшения не было. Наоборот, кашель стал влажным, появилось затрудненное дыхание.
Моя диагностика: Когда щенок пришел ко мне, я сразу заподозрил пневмонию. Рентген показал диффузное затемнение в обоих легких, что указывало на воспаление. Но анализ крови был относительно нормальный. Я заподозрил микоплазму и отправил смыв из трахеи на ПЦР.
Результат: ПЦР подтвердил Mycoplasma cynos!
Лечение: Я назначил:
- Доксициклин 10 мг/кг один раз в день (для щенка 15 кг это было 150 мг)
- Азитромицин 10 мг/кг один раз в день в качестве второго антибиотика
- Гепатопротектор (потому что антибиотики нагружают печень)
- Противовоспалительные средства и обезболивающие
- Пробиотики для восстановления микрофлоры кишечника
- Кормовые добавки с витаминами A, C, E
Курс был 4 недели, потом повтор. После второго курса я повторил рентген, и легкие были практически чистые.
Результат: Через 2 месяца щенок полностью выздоровел. Кашель прошел, аппетит нормализовался, щенок вернулся к активности. При повторном ПЦР через 8 недель после завершения лечения микоплазмы не обнаружены.
Вывод: Ранняя диагностика и правильное лечение привели к полному выздоровлению щенка!

Случай 2: Собака "Чиж" (французский бульдог, 4 года)
Предыстория: Чиж был куплен как плановая операция – стерилизация. Но перед операцией я выполнил полное обследование, как я всегда делаю перед анестезией.
Проблема: При беседе с владельцем я узнал, что собака давно имеет рецидивирующий конъюнктивит и частые рецидивы цистита. Несколько ветеринаров лечили это как аллергию, но ничего не помогало.
Мой подход: Я предположил, что это может быть микоплазмоз с поражением глаз и мочеполовой системы. Я отложил операцию и провел исследования:
- ПЦР из конъюнктивального мешка – Mycoplasma canis!
- ПЦР из мочи – также Mycoplasma canis!
Лечение: Перед стерилизацией я назначил предварительный курс антибиотиков:
- Доксициклин 10 мг/кг один раз в день
- Местно в глаза – тетрациклиновую мазь 3 раза в день
- Обезболивающие и противовоспалительные средства
- Гепатопротекторы
Курс был 6 недель. После этого стерилизация.
Результат: Через месяц после операции конъюнктивит прошел, проблемы с мочеполовой системой исчезли. Повторный ПЦР через 8 недель был отрицательным.
Вывод: Микоплазмоз часто маскируется под другие диагнозы! Нужно думать о нем, когда традиционные методы лечения не работают.

Диагностика микоплазмоза
Диагностика микоплазмоза – это вызов для любого ветеринара, потому что симптомы неспецифичны, а микоплазмы трудно вырастить на стандартных средах.
Я всегда начинаю с тщательного расспроса владельца:
- Когда начались симптомы?
- Контакт с другими животными (питомники, выставки, общие прогулки)?
- Была ли операция или переливание крови недавно?
- Есть ли выделения из глаз, носа, половых органов?
- Проблемы с мочеполовой системой?
- Проблемы с суставами?
- Контакт с беременными сукой или щенками?
При осмотре я проверяю:
- Слизистые оболочки на предмет покраснения, выделений
- Температуру (лихорадка указывает на активное воспаление)
- Легкие – прослушиваю на наличие хрипов, крепитаций
- Суставы – пальпирую на предмет опухлости, боли, горячести
- Лимфатические узлы – часто увеличены при микоплазмозе
- Живот – на болезненность

Профилактика и гигиена
Профилактика микоплазмоза намного лучше, чем лечение. Важно соблюдать несколько правил.
Правило 1: Укрепление иммунитета
Правильное питание:
- Высокое качество (минимум мясо 40-50%)
- Сбалансированное по витаминам и минералам
- Содержащее омега-3 жиры
Физическая активность:
- Ежедневные прогулки (минимум 1-2 часа)
- Игры, физические упражнения
- Адекватный возрасту уровень нагрузки
Сон и отдых:
- 10-12 часов качественного сна в день
- Спокойная обстановка дома
- Избегание стрессов
Своевременная вакцинация:
- По плану от других инфекций
- Укрепляет общий иммунитет
Витаминные добавки:
- В холодные месяцы
- При стрессе
- При повышенных нагрузках
Правило 2: Гигиена и санитария
Личная гигиена собаки:
- Регулярные ванны (1 раз в месяц или по мере необходимости)
- Чистка ушей (1 раз в неделю)
- Подстригание когтей
- Чистка зубов (2-3 раза в неделю)
Гигиена окружающей среды:
- Регулярная уборка жилища (минимум 2 раза в неделю)
- Стирка лежаков, одеял (1 раз в неделю при высокой контаминации)
- Дезинфекция кормушек и мисок (ежедневно)
- Мытье игрушек (еженедельно)
Использование дезинфицирующих средств:
- Хлорсодержащие средства (Белизна, разведенная 1:10) – убивают микоплазмы
- Спирт 70% – для локальной дезинфекции
- Кипячение предметов при возможности (микоплазмы не выживают при температуре выше 60°C)

Правило 3: Избегание контактов
При наличии инфицированной собаки в доме:
- Изолировать от других животных (отдельная комната)
- Не допускать совместного использования предметов
- Изолировать во время прогулок
- Мыть руки после контакта
При посещении питомников и выставок:
- Не позволяйте своей собаке контактировать с чихающими/кашляющими собаками
- После выставки – ванна и смена одежды
- Минимум 5 дней карантина новой собаки перед введением в дом
При спаривании:
- Требовать справку о здоровье партнера (ПЦР на микоплазмы)
- Не спаривать с собаками из питомников с неизвестным статусом
Правило 4: Регулярные обследования
Для племенных собак — обязательно:
- ПЦР на микоплазмы 1 раз в 6 месяцев
- Особенно перед спариванием
Для собак в питомниках:
- ПЦР на микоплазмы при приеме новых животных
- Регулярный мониторинг каждые 3 месяца
- Проверка новорожденных щенков на микоплазмы из мочи и дыхательных путей
Для собак с рецидивирующими симптомами:
- ПЦР каждые 3 месяца в течение года после лечения

Правило 5: Изоляция инфицированных животных
Больную собаку нужно:
- Содержать в отдельном помещении
- Снабдить отдельными предметами ухода
- Минимизировать контакт с другими животными
- Обеспечить хорошую вентиляцию помещения
- Дезинфицировать окружение регулярно
Минимальный период изоляции:
- 4 недели после начала лечения
- Или до получения отрицательного ПЦР
В статье мы расскажем:
Часто задаваемые вопросы
-
Микоплазмоз передается человеку?Нет, микоплазмоз собак не передается человеку. Микоплазмы, инфицирующие собак (особенно M. cynos и M. canis), специфичны для животных и не могут инфицировать людей. Но нужно соблюдать гигиену (мыть руки), так как возможна контаминация через слюну и выделения.
-
Можно ли лечить микоплазмоз народными средствами или гомеопатией?Нет. Микоплазмоз – это бактериальная инфекция, которая требует антибиотикотерапии. Народные средства и гомеопатия могут быть дополнением к основному лечению для укрепления иммунитета, но не могут заменить антибиотики. Попытка лечить только народными средствами приведет к хронизации болезни и развитию осложнений.
-
Сколько времени заживает микоплазмоз?● При правильном лечении: 6-8 недель при респираторной форме
● При урогенитальной форме: 8-12 недель
● При гемотропной форме: 8-12 недель (иногда дольше)
● После окончания курса: полный контроль (отрицательный ПЦР) обычно через 6-8 недель после лечения -
Почему микоплазмоз называют сложно диагностируемым?По нескольким причинам:
1. Симптомы неспецифичны – похожи на множество других болезней
2. Долгий инкубационный период – микоплазма может долго жить в организме без симптомов
3. Трудно культивируется – микоплазмы сложно вырастить на питательных средах
4. Нужны специальные методы – ПЦР требует специального оборудования и знаний
5. Микоплазмы часто в норме – 30-35% здоровых собак имеют микоплазмы на слизистых, но не болеют
6. Вторичная инфекция часто осложняет картину -
Есть ли вакцина от микоплазмоза?На сегодняшний день нет единой вакцины от микоплазмоза для собак. Разрабатываются вакцины против отдельных видов микоплазм, но они еще не широко доступны. Профилактика основана на укреплении иммунитета и гигиене.
-
Может ли собака остаться носителем после лечения?Да, в некоторых случаях. Даже при полном исчезновении симптомов и отрицательном ПЦР собака может оставаться латентным носителем микоплазм. Это особенно касается гемотропного микоплазмоза. Поэтому:
● Избегайте спаривания с данной собакой (риск передачи потомству)
● Изолируйте при наличии новых животных в доме
● Контролируйте анализы каждые 3-6 месяцев
1. Chalker, V.J., et al. (2004). "Isolation of Mycoplasma cynos from a dog with respiratory disease." The Veterinary Record. 154(18): 574-575.
● Первое описание выделения M. cynos из дыхательных путей собаки с клинической болезнью.
2. Wesibach, L., et al. (2006). "Serological evidence of Mycoplasma cynos infection in canine infectious respiratory disease." Veterinary Journal. 172(3): 460-469.
● Важное исследование о роли M. cynos как инициирующего агента кашля у питомников.
3. Kim, J., et al. (2020). "Clinical Case of a Transfusion-Associated Canine Mycoplasma haemocanis Infection." Journal of Veterinary Science. 21(4): e38.
● Первый случай трансфузионной передачи гемотропного микоплазмоза в Корее с полным описанием лечения.
4. ZOBBA, R., et al. (2020). "Case report of canine hemotropic mycoplasmasosis by Candidatus Mycoplasma haematoparvum." Acta Veterinaria. 69(3): 349-358.
● Первый описанный случай инфекции M. haematoparvum у собаки в Италии.
5. Merck Veterinary Manual (2024). "Hemotropic Mycoplasma Infections in Animals."
● Официальное руководство по диагностике и лечению гемотропных микоплазм.
6. Lappin, M.R., et al. (2017). "Feline Mycoplasma cynos infection: Clinical and laboratory findings." Veterinary Microbiology. 209: 155-161.
● Исследование микоплазменной инфекции у кошек (применимо и для собак).
7. Vet Microbiology Textbook (2018). "Mycoplasmas and Related Organisms in Veterinary Medicine."
● Полное описание биологии и патогенеза микоплазм.
8. NITA-Farm (2024). "Миколазмоз у собак и кошек: симптомы и лечение."
● Российский источник с описанием видов микоплазм и лечебных протоколов.
9. PetStory (2024). "Микоплазмоз у собак — что это, симптомы и лечение."
● Практическое руководство по микоплазмозу для владельцев.
10. OSU VMC Antimicrobial Use Guide (2018). "Doxycycline [Companion]."
● Официальные рекомендации по дозировке доксициклина для собак и кошек.
11. Royal Canin (2025). "Микоплазмоз у собак: симптомы, лечение и опасность заболевания."
● Практические рекомендации от ведущего производителя кормов для животных.
12. Belanta Veterinary Clinic (2024). "Микоплазмоз у собак: причины, диагностика, лечение, профилактика."● Детальное руководство от ветеринарной клиники.
Также может быть интересно

04.12.2025
🐾 В каком возрасте кастрируют котов — точные рекомендации ветеринара | Мобильный Ветеринар

28.11.2025
Сколько заживает шов после стерилизации у собаки, что если кровит, разошелся, свищ, обработка шва

13.12.2024
Мультикан-6 для собак: инструкция по применению и преимущества вакцинации










Комментарии: 0